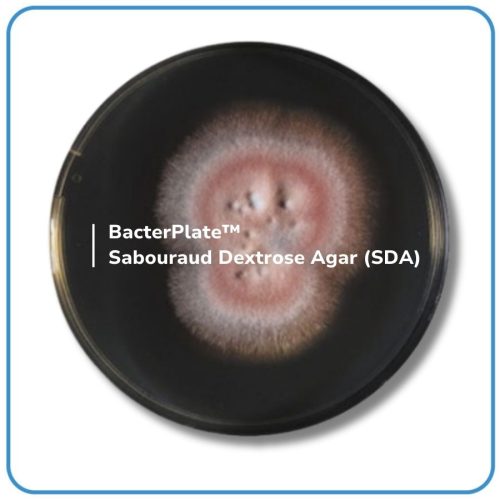

BacterPlate™ Sabouraud Dextrose Agar (SDA)
Mã: 05027
Mã đặt hàng/sản phẩm: 4102014
Số lượng tối thiểu: 1
- BacterPlate™ Sabouraud Dextrose Agar (SDA) là môi trường cổ điển dùng để nuôi cấy, phân lập và nhận diện nấm men và nấm mốc trong các thử nghiệm vô trùng của các sản phẩm dược phẩm và mỹ phẩm. Môi trường này cũng được sử dụng trong việc phát hiện đặc hiệu Candida albicans trong các sản phẩm dược phẩm. Lấy mẫu không khí các chỉ tiêu kiểm soát phòng sạch.
- Thành phần trong 1L môi trường (tham khảo): Dextrose; Pancreatic digest of animal tissues; Pancreatic digest of casein; Agar. pH của môi trường hoàn chỉnh ở 25°C: 5,6 ± 0,2.
- Quy cách: 10 đĩa/ hộp hoặc theo yêu cầu của khách hàng.
- Bảo quản lưu trữ: 2 – 8°C.
- Vận chuyển: Nhiệt độ môi trường.
- Hạn sử dụng: 04 tháng kể từ ngày sản xuất.
Danh sách đặt hàng

BacterPlate™ Sabouraud Dextrose Agar (SDA)
Mã: 4102014
Đơn vị: Đĩa
| Tên sản phẩm | Hình ảnh | Mã đặt hàng/sản phẩm | Đơn vị tính | Số lượng | Chọn vào giỏ hàng |
|---|---|---|---|---|---|
| BacterPlate™ Sabouraud Dextrose Agar (SDA) | | 4102014 | Đĩa |
